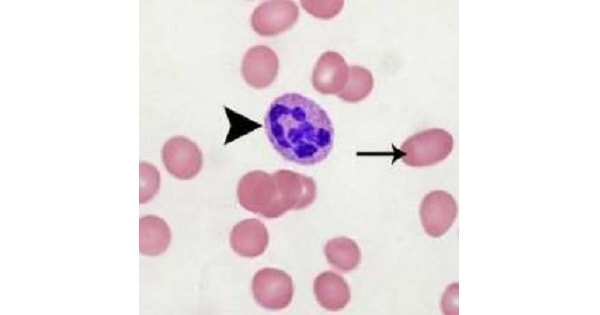
Image Based Question

Image Based Question-66225
Question A newborn had a bilious vomiting after 6 hours of birth. X-ray of the abdomen shows as represented in the picture below. This is a feature of ? A. Pyloric stenosis. B. Duodenal atresia. C. Ileal atresia. D. Esophageal atresia. Show Answer Correct Answer » B Explanation Ans:B. Duodenal atresia “Double bubble” sign […]
Image Based Question-66225 Read More »